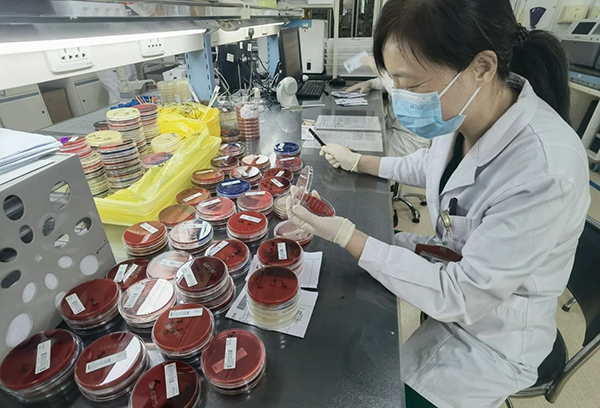

您所在的位置:
首页
>>>> >>
部门动态
【假期我在岗】山东第一医科大学附属省立医院:“医”线坚守 护佑生命(二)
他们身着白衣
他们坚守岗位
他们以仁心仁术
守护着每一个生命的健康与安宁
用专业的技能和无私的奉献
诠释着医者的使命与担当
为满足广大群众节日期间的健康需求,确保人民群众度过一个欢乐祥和的节日,在国庆假日期间,山东第一医科大学附属省立医院(山东省立医院)广大医务人员在各自的岗位上有条不紊地忙碌着,守护群众的健康与安宁,用实际行动诠释医者仁心、医者使命。
急救中心
中心院区





东院区




门诊




器官移植肝胆外二科


重症医学一科



东院区产科


东院保健内分泌




医学影像科






临床医学检验部

病理科



后勤管理部



保卫部




